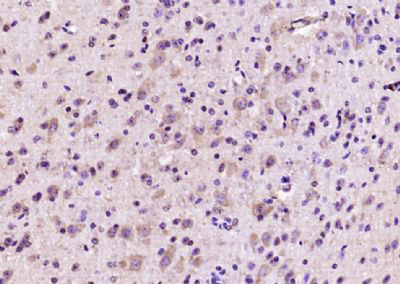
产品细节图片1

相关产品推荐更多 >
万千商家帮你免费找货
0 人在求购买到急需产品
- 详细信息
- 文献和实验
- 技术资料
- 供应商:
江西江蓝纯生物试剂有限公司
- 库存:
200
- 克隆性:
单克隆
- 保质期:
1年
- 抗体英文名:
ETFA
- 抗体名:
电子转移黄素蛋白α抗体
- 适应物种:
人/动物/植物
- 应用范围:
WB,ELISA等
- 浓度:
1mg/ml
- 保存条件:
-20 °
- 规格:
100ul/200ul
| 规格: | 100ul | 产品价格: | ¥1580.0 |
|---|---|---|---|
| 规格: | 200ul | 产品价格: | ¥2480.0 |
英文名称 : ETFA
中文名称 : 电子转移黄素蛋白α抗体
别 名 : ETF-alpha; Electron transfer flavoprotein subunit alpha; electron-transfer-flavoprotein, alpha polypeptide; mitochondrial; Alpha ETF; Alpha-ETF; Electron transfer flavoprotein alpha polypeptide; Electron transfer flavoprotein alpha subunit; Electron transfer flavoprotein subunit alpha; Electron transfer flavoprotein subunit alpha mitochondrial; Electron transfer flavoprotein subunit alpha, mitochondrial; Electron transferring flavoprotein alpha polypeptide; EMA; ETFA; ETFA_HUMAN; GA2.
研究领域 : 肿瘤 细胞生物 免疫学 信号转导 线粒体
抗体来源 : Rabbit
克隆类型 : Polyclonal
交叉反应 : Human, Mouse, Rat, Dog, Pig, Cow, Horse, Rabbit, Sheep, Xenopuslaevis
产品应用 : ELISA=1:500-1000 IHC-P=1:400-800 IHC-F=1:400-800 ICC=1:100-500 IF=1:50-200 (石蜡切片需做抗原修复)
not yet tested in other applications.
optimal dilutions/concentrations should be determined by the end user.
分 子 量 : 37kDa
细胞定位 : 细胞浆 线粒体
性 状 : Lyophilized or Liquid
浓 度 : 1mg/ml
免 疫 原 : KLH conjugated synthetic peptide derived from human ETFA:184-260/333
亚 型 : IgG
纯化方法 : affinity purified by Protein A
储 存 液 : 0.01M TBS(pH7.4) with 1% BSA, 0.03% Proclin300 and 50% Glycerol.
保存条件 : Store at -20 °C for one year. Avoid repeated freeze/thaw cycles. The lyophilized antibody is stable at room temperature for at least one month and for greater than a year when kept at -20°C. When reconstituted in sterile pH 7.4 0.01M PBS or diluent of antibody the antibody is stable for at least two weeks at 2-4 °C.
PubMed : PubMed
产品介绍 : ETFA participates in catalyzing the initial step of the mitochondrial fatty acid beta-oxidation. It shuttles electrons between primary flavoprotein dehydrogenases and the membrane-bound electron transfer flavoprotein ubiquinone oxidoreductase. Defects in electron-transfer-flavoprotein have been implicated in type II glutaricaciduria in which multiple acyl-CoA dehydrogenase deficiencies result in large excretion of glutaric, lactic, ethylmalonic, butyric, isobutyric, 2-methyl-butyric, and isovaleric acids. Two transcript variants encoding different isoforms have been found for this gene. [provided by RefSeq, Jul 2008].
Function:
The electron transfer flavoprotein serves as a specific electron acceptor for several dehydrogenases, including five acyl-CoA dehydrogenases, glutaryl-CoA and sarcosine dehydrogenase. It transfers the electrons to the main mitochondrial respiratory chain via ETF-ubiquinone oxidoreductase (ETF dehydrogenase).
Subunit:
Heterodimer of an alpha and a beta subunit.
Subcellular Location:
Mitochondrion matrix.
Post-translational modifications:
The N-terminus is blocked
DISEASE:
Defects in ETFA are the cause of glutaric aciduria type 2A (GA2A) [MIM:231680]; also known as glutaricaciduria IIA. GA2A is an autosomal recessively inherited disorder of fatty acid, amino acid, and choline metabolism. It is characterized by multiple acyl-CoA dehydrogenase deficiencies resulting in large excretion not only of glutaric acid, but also of lactic, ethylmalonic, butyric, isobutyric, 2-methyl-butyric, and isovaleric acids.
Similarity:
Belongs to the ETF alpha-subunit/FixB family.
SWISS:
P13804
Gene ID:
2108
Important Note:
This product as supplied is intended for research use only, not for use in human, therapeutic or diagnostic applications.
Involvement in disease:Defects in ETFA are the cause of glutaric aciduria type 2A (GA2A); also known as glutaricaciduria IIA. GA2A is an autosomal recessively inherited disorder of fatty acid, amino acid, and choline metabolism. It is characterized by multiple acyl-CoA dehydrogenase deficiencies resulting in large excretion not only of glutaric acid, but also of lactic, ethylmalonic, butyric, isobutyric, 2-methyl-butyric, and isovaleric acids.
产品图片
风险提示:丁香通仅作为第三方平台,为商家信息发布提供平台空间。用户咨询产品时请注意保护个人信息及财产安全,合理判断,谨慎选购商品,商家和用户对交易行为负责。对于医疗器械类产品,请先查证核实企业经营资质和医疗器械产品注册证情况。
 文献和实验
文献和实验双抗体夹心ELISA法检测待测样品sTNF- α 含量 【基本原理】 选用两株针对TNF-α分子不同位点的单克隆抗体,即McAb1 (包被抗体)与McAb2 (酶标抗体)。先用McAb1 包被固相载体,使待测sTNF-α与之特异性结合,然后再加入辣根过氧化物酶(HRP)标记的McAb2 ,则形成McAb1 -sTNF-α -HRP标记McAb2 复合物,再加入HRP底物,则酶催化底物显色,测定样品与标准品光密度值(即OD值),绘制标准曲线,即可从标准曲线中
实验试剂 1. 包被抗体McAb1 :使用时用包被液作适当稀释(如1:100)。 2. 酶标抗体McAb2 :以辣根过氧化物酶(HRP)标记。使用时用稀释液作适当稀释,其稀释度根据预试验结果而定。 3. rhuTNF-α标准品:已知含量的rhuTNF-(10ng/ml),使用时用稀释液作倍比稀释成7个浓度:5 ng/ml,2.5 ng/ml,1.25 ng/ml,625pg/ml,312 pg/ml,156 pg/ml
单克隆抗体(McAb)亲和层析柱纯化重组人α2a干扰素(rHuIFN-α2a)
重组人α干扰素作为一种具有广谱抗病毒、抑制肿瘤细胞生长及免疫调节作用的 细胞因子 新型药物,已在国内外广泛投入临床应用,并取得了显著的疗效。国际上对用于临床的重组干扰素的纯度要求很高,美国NIH规定必须在90%以上,因此生产者普遍采用亲和层析纯化法。我们研制了rHuIFN-α2a的McAb 3F1,与CNBr活化的Sepharose 4B交联制成亲和层析柱,经1年60余次较大规模试用表明具有较理想的亲和层析纯化rHuIFN-α2a的性能,达到
 技术资料
技术资料暂无技术资料 索取技术资料









